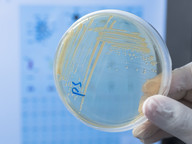

正在顯示 171 至 180 筆資料(共 272 筆資料)

相信大家都遇到過趕路時,一不小心踩到前方路人鞋子的尷尬情況。香港城市大學(香港城大)參與領導的一項研究便發現,原來當人群在彼此安全距離不足的情況下,會自動調節步伐,出現稱為「同步」(synchronisation)的自組織現象,從而避免與前方的人碰撞。研究成果為預防「行人- 建築物」共振問題,及為保障行人公共安全帶來啟示。

由香港城市大學(香港城大)科學家領導的聯合研究團隊早前便研發出一套光催化系統,在陽光照射下模擬光合作用,配合他們新研發的複合光催化劑,能夠從二氧化碳選擇性和有效地生產出燃料甲烷(methane, CH4),於首8小時的反應過程中,甲烷的產量增加近一倍。

由香港城市大學(香港城大)科學家領導的聯合研究團隊,早前成功研發出一種超穩定的錳基正極材料,比目前常用的鈷和鎳正極材料更高容量和耐用,而且充放電次數增加一倍後仍可維持9成的充電容量,為開發低成本、高效的鋰電池錳基正極材料,打開新方向。

鑽石(又名金剛石)是大自然裡最硬的物料,而出乎許多人的意料,它其實有巨大潛力成為極佳的電子材料。由香港城市大學(香港城大)領導的最新研究便首次成功展示了以納米力學的方式,對微加工的金剛石陣列施加極大而均勻的彈性拉伸應變,以應用於微電子、光電和量子資訊器件。

由香港城市大學(香港城大)科學家共同領導的聯合研究團隊,開發出一種可以重建和以三維(3D)圖像呈現細胞形狀隨著時間而變化的新型運算工具,令分析過程從需要人手操作數百小時,加快至只需用電腦數小時便可完成。此運算工具顛覆了生物學家分析圖像數據的方式,有助推進細胞和發育生物學、如癌細胞生長的進一步研究。

由香港城市大學(香港城大)科學家領導的聯合研究團隊早前運用數學模型,探討並分析疾病的傳播、市民對疾病的警覺性與後續行動,以及大眾傳媒和意見領袖傳遞疾病資訊之間的關係,冀為全球應對新型冠狀病毒與其他類似的傳染病作出貢獻。

由香港城市大學(香港城大)領導的聯合研究,建立了一套耗電量極低的人工視覺系統,以模擬人類大腦,並成功執行了數據密集的認知任務。研究團隊的實驗成果,將可為新一代人工智能(artificial intelligence, AI)器件,提供具潛力的操作系統。
全球人口不斷增加,或現糧食危機之聲不絕於耳,除了氣候變化、農地減少,世界糧食安全亦受細菌性植物病害所威脅。由香港城市大學(香港城大)科學家領導的聯合研究團隊,早前已經找出令一種病原菌致病的關鍵蛋白質轉錄因子,近日再下一城,揭示出該病原菌的毒力調節機制,有助開發用以防治的抗菌新藥,並促進日後有關該病原菌和其他病原菌轉錄因子的研究。

對強力抗生素呈耐藥性的「超級細菌」是全球公共衛生的一個計時炸彈。由香港城市大學(香港城大)科學家領導的聯合研究團隊,針對其中一組抗生素耐藥性基因追本溯源,早前發表研究結果,鎖定了其中一種細菌為該組耐藥性基因的潛在來源,並研究其傳播機制,希望有助阻截其傳播。

香港城市大學(香港城大)科學家領導的一支聯合研究團隊,近日研發出在物件表面噴塗一層膠水般的磁性噴霧,便可輕易地將物件變為微型機械人。在磁場的驅動下,化身成微型機械人的物件可以於不同的表面上爬行、行走或者滾動。這種磁性噴霧生物兼容,而且所形成的外層可於有需要時崩解成粉末,令這項技術於生物醫學上的應用,例如在導管插入和傳輸藥物等方面,極具潛力。